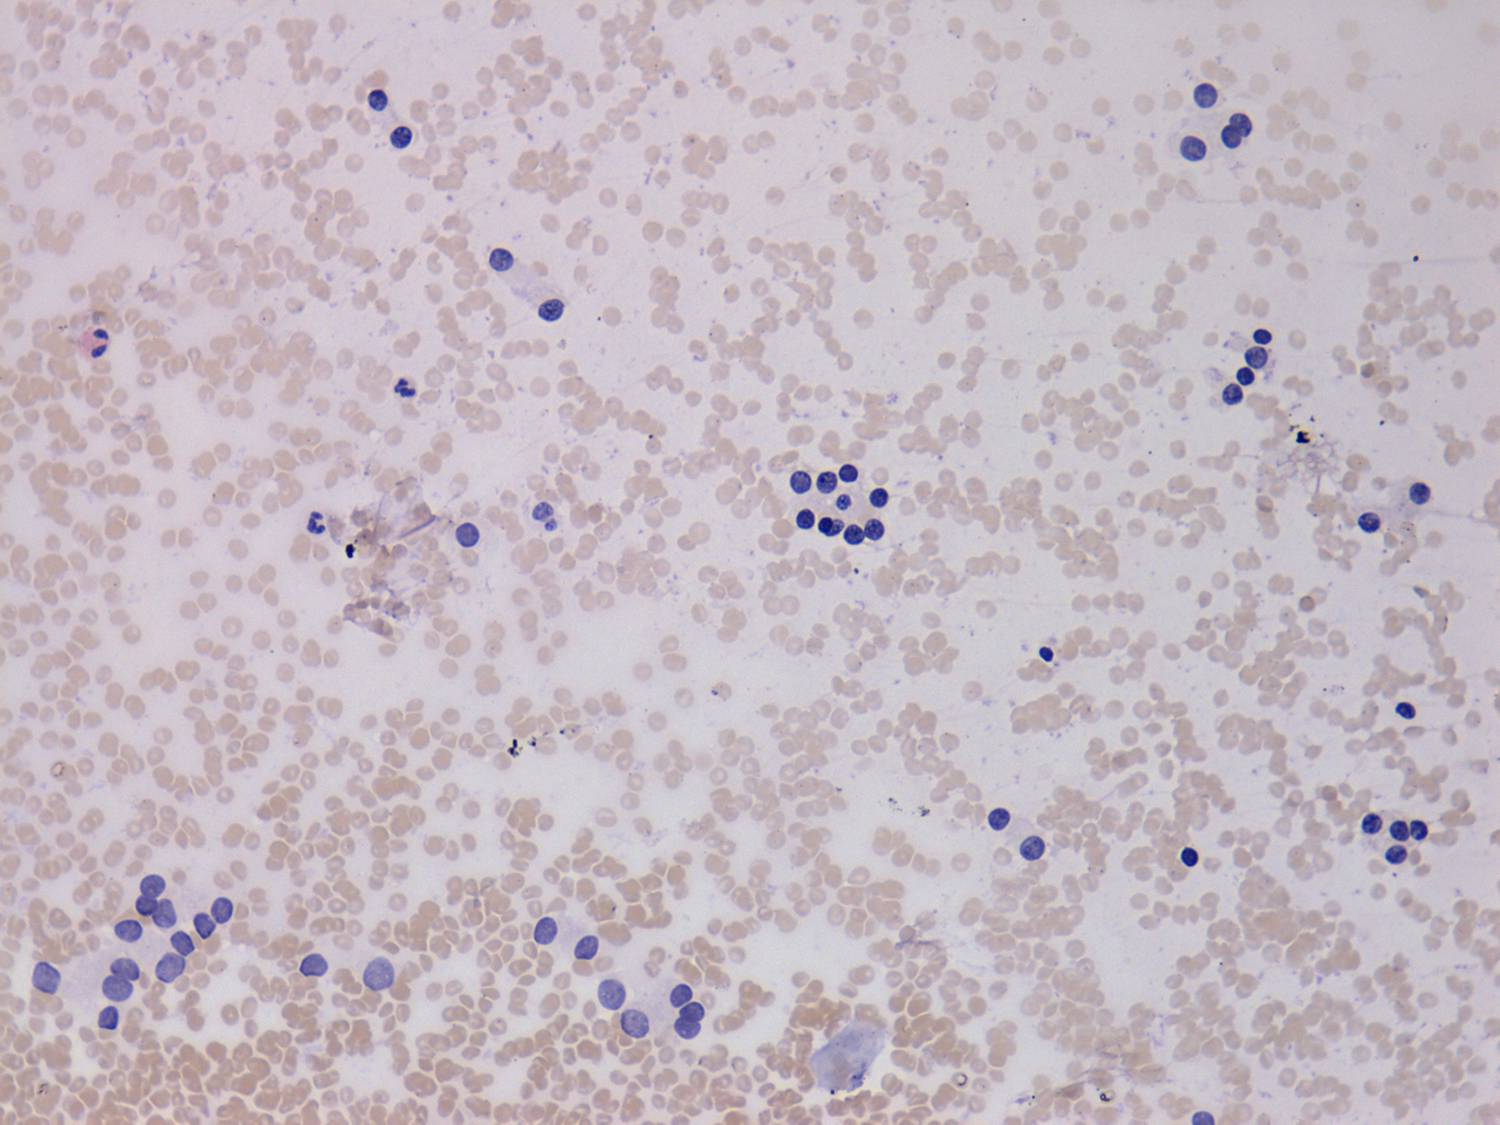

Follicular adenoma - Case 36. (cytologic picture 2)
|
|

|

|
|
Pap-smear, 200x. Follicular cells present anisonucleosis: dark and small nuclei occur mixed with light and larger nuclei. There is a cell group in the center composed of 2 or 3 microfollicles.